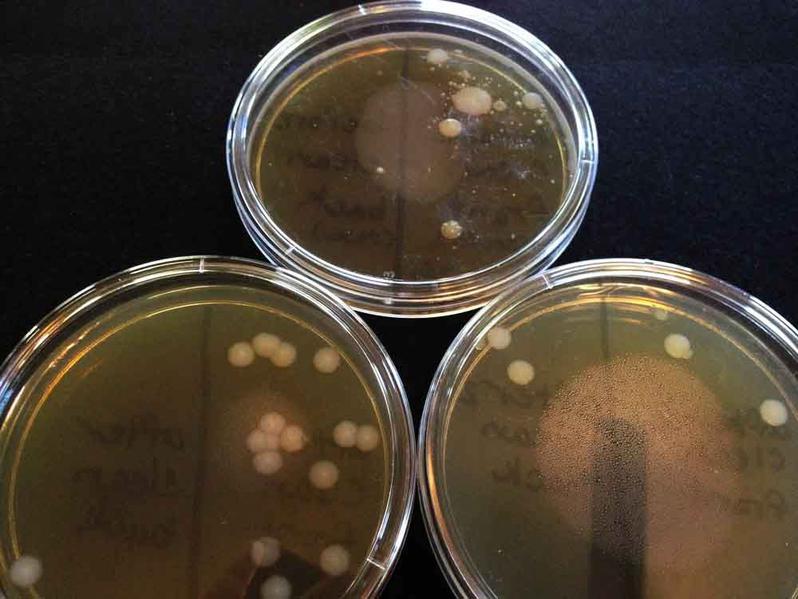

| ||||
How Well Do Antibacterial Wipes Disinfect Cell Phones
and Other Touch Screen Devices?
Experimental Methods and Results
HOUSEHOLD MICRO from Science Prof Online
As a microbiologist and a mom of two small children with allergies and asthma, I am always looking for ways to make our home and habits cleaner and healthier.
This page will continue to grow as the results of these microbial control experiments become available. Currently we are evaluating the effectiveness of different types of disinfectant wipes for sanitizing cell phones. Check back frequently and Like Us on Facebook.
See "Microbiology In the Home" for more interesting home micro experiments.
Article Summary: People touch their cell phones and other electronic devices throughout the day. What is the best way to sanitize touch screens? Here's our experiment, great for science home schooling or classroom use.
How Well Do Disinfecting Wipes Kill Bacteria on Touch Screen Devices?
 | ||||
You have free access to a large collection of materials used in a college-level introductory microbiology course. The Virtual Microbiology Classroom provides a wide range of free educational resources including PowerPoint Lectures, Study Guides, Review Questions and Practice Test Questions.
Page last updated: 8/2014
SCIENCE PHOTOS
SPO VIRTUAL CLASSROOMS
 | ||||||
 | ||||||
 | ||||||
ANOTHER HOME MICROBIOLOGY EXPERIMENT FROM SPO
Yes!
TSY agar with sample from dirty dishes on top (note bacterial colonies that grew), and sample from cleaned dishes on bottom.
experiment was repeated and the samples plated on TSY agar. The "before cleaning" floor sample is on the left (note numerous bacterial colonies) and the "after cleaning" sample on right.
Additional Microbiology in the Home Resources
- How Do Antibiotics Work to Kill Bacteria? Class Notes article from Science Prof Online.
- Can Changes in the Weather Make a Person Sick?, SPO article
- Why Do People Catch Cold Viruses in Summer?, SPO article
- Microbial Control Laboratory Exercise Main Page from the Virtual Microbiology Classroom.
Experiments: Sanitizing an iPhone Using Disinfectant Wipes
Materials Required
- Petri dishes
- sterile TSY agar bacterial growth media
- sterile swabs
- sharpie marker
- plastic bags with zip seal (quart or gallon)
The first three items on this list can be obtained, as part of the "Bacteria Experiment Kit" from the Home Science Tools website. The kit is reasonably priced and comes with instructions for preparing the agar and pouring it into Petri dishes.
Preliminary Experiment
Before putting much thought into experimental design, I did a quickie experiment to see how well the wipes that we typically use in our home (Seventh Generation Disinfecting Wipes) kill bacteria on my iPhone. This brand of wipes lists 0.05% Thymol, a component of thyme oil, as an active ingredient.
Experimental Method
I did not get a sample from the phone before cleaning it (bad design), but did obtain four samples from my phone. Separate sterile swabs were used to obtain samples from:
- phone screen after cleaning with one wipe and letting it dry
- phone case after cleaning with same wipe and letting it dry
- phone screen after cleaning a second time with a new wipe and letting it dry
- phone case after cleaning with same second wipe, and letting it dry
I purposely used only one wipe for the entire phone (screen and case) because it is more realistic as to how a person might typically clean a cell phone.
The swabbed samples were then streaked onto Petri plates of TSY bacterial growth agar, and then the plates were placed bottom-side up, in a warm area of the house to encourage growth and checked days later for bacterial growth.
Experimental Results
Although it would have been helpful to have a "before cleaning" sample. (Oops!) The following photos do show a few clear results:
- The screen of the phone had much more bacterial growth than the case.
- Although cleaning with one wipe still left many bacteria, a second cleaning, with a second wipe, destroyed nearly all bacteria.
 | ||||
Young children are natural born scientists, full of curiosity! Join the at-home experiments and explorations of a scientist mom & her kids.
 | ||||
SPO HOME SCIENCE PROJECT
BULLFROG METAMORPHOSIS
Currently we are raising bullfrog tadpoles and documenting their metamorphosis into adult frogs!
Click here to take a look!
Image on left shows four samples taken. Plate on the far left shows the bacterial growth after cleaning with one disinfecting wipe. The front (screen) of the phone definitely shows more growth than the back (case). And a second cleaning (the plate on the right) resulted in only one bacterial colony) on the screen of the phone.
This image shows both plates flipped over to make it easier to see the bacterial growth on each plate. Each bacterial colony (typically a round dot on the plate) represents one bacterium sampled that has divided many times, resulting in millions of bacteria of that same type.
Because I performed this experiment on the spur of the moment, without putting much thought into its design, I chose to repeat the experiment with modifications. Below are the methods and results of a more carefully designed cell phone sanitizing experiment.
Experiment #1: Using Seventh Generation Disinfecting Wipes to Clean iPhone
Supplies Used
- 1 black permanent marker
- 6 sterile swabs
- 6 Petri dishes with 1/4" TSY bacterial growth medium
Experimental Methods
Cleaning the Phone: The phone was cleaned using a Seventh Generation disinfectant wipe. The wipe was rubbed over the screen in 25 small circles and then rubbed over the case using the same method. I again purposely used one wipe for the entire phone (screen and case) because it is more realistic as to how a person would likely clean a cell phone. After obtaining samples from the cleaned cell phone, it was cleaned a second time, with a new wipe, allowed to dry, and then re-sampled.
Obtaining Samples: The following samples were obtained from the iPhone screen, and separately from the iPhone case:
- before the phone was cleaned (and not cleaned previous 4 days)
- after cleaning with disinfectant wipe, and allowing to dry
- after cleaning again with a second disinfectant wipe, and allowing to dry
For each sample that was obtained, the sterile swabbed was run back and forth 25x, over the surface being tested .
Plating and Storing Samples: Each swabbed sample was streaked in a tight, back-and-forth pattern onto 1/2 of a Petri plate of TSY bacterial growth agar. The completed plates were placed bottom-side up, in a warm area of the house, to encourage growth and then checked four days later.
Experimental Results
Streaking a sample onto bacterial growth agar, will, if bacteria are present, result in a bacterial colony. A bacterial colony is a visible spot, consisting of millions of bacteria, that have arisin from one sampled bacterium.
We plan on running three trials using the Seventh Generation sanitizing wipes, and then additional trials with different brands of wipes. Below are the results for of first two Seventh Generation wipe experiments. The third trial is currently underway.
ATTENTION!: Please see the section on Safety Measures for Working with Live Bacteria
before attempting this experiment yourself!
Safety Measures When Working With Live Bacteria
Please read this section carefully before carrying out the experiment outlined above. Although these plates will be growing bacteria present on hands, once the bacteria begin growing on the agar plates, they will be present in much higher numbers than a person would normally encounter. Therefore, there are some important safety precautions to keep in mind:
- Wear safety goggles and protective gloves when handling plates that are growing bacteria.
- Never open the plates after placing the sample on the agar. Bacteria will be present in large numbers. Some can become airborne and be breathed in or land on areas of the body close to an open plate.
- Keep plates out of the reach of small children and pets.Talk to children about these safety precautions and make sure they know not to ever handle the plates without adult supervision.
- You may place a rubber band around the plates to reduce the likelihood that they will accidentally fall open.
- The top of the refrigerator can be a good place to store incubating plates, as it is up high and usually a bit warm.
- Placing incubating plates in open plastic bag (so aerobic bacteria can get oxygen) is a good measure to keep them safer and reduce odor (bacteria are stinky).
- When the experiment is finished, and you are done with the plates, place them in a zipped up plastic bag (Zip-loc) in the trash. They will run out of food and water eventually and die, but not before generating a lot of stink.
TRIAL #1: Left Photo Above: Three plates of TSY bacterial growth agar with samples taken from an iPhone. 1. Top plate "before cleaning" sample, with front/screen sample on left side of plate and back/case sample on right.; 2. Lower left plate "after first cleaning" with one disinfecting wipe, screen sample on left side of plate, case sample on right. 3. Lower right plate "after second cleaning" with another disinfectant wipe, screen sample on left, case on right. Right Photo Above: Plates flipped over to view bacterial colonies from above. Results Summary: Plate from the "dirty" sample shows variety of bacterial colonies, from the screen sample, with very little growth from the case. The "after first cleaning" sample still showed bacteria on the screen, but less variety, all bacterial colonies looked the same. In the "after second cleaning" samples bacteria were almost entirely eliminated from the phone.
TRIAL #2: Left Photo Above: Three plates of TSY bacterial growth agar with samples taken from an iPhone. 1. Top plate "before cleaning" sample, with front/screen sample on left side of plate and back/case sample on right.; 2. Lower left plate "after first cleaning" with one disinfecting wipe, screen sample on left side of plate, case sample on right. 3. Lower right plat "after second cleaning" with another disinfectant wipe, screen sample on left, case sample on right. Right Photo Above: Plates flipped over to view bacterial colonies from above. Results Summary: This experiment reveals a much dirtier phone, with a large number and variety of bacteria on the "before cleaning" plate. The "after first cleaning" sample still showed bacteria on the screen, but fewer number and variety. The "after second cleaning" samples show that bacteria were almost entirely eliminated from the phone touch screen, however the case sample still showed a number of bacterial colonies.
 | ||||
Our Fav New Kid Science App!
Amoeboid
Free, fun and addictive, this slyly educational app teaches kids about microbes. The game takes place in a Petri dish where Phoebe the Amoeba encounters many types of protists who help her earn points.